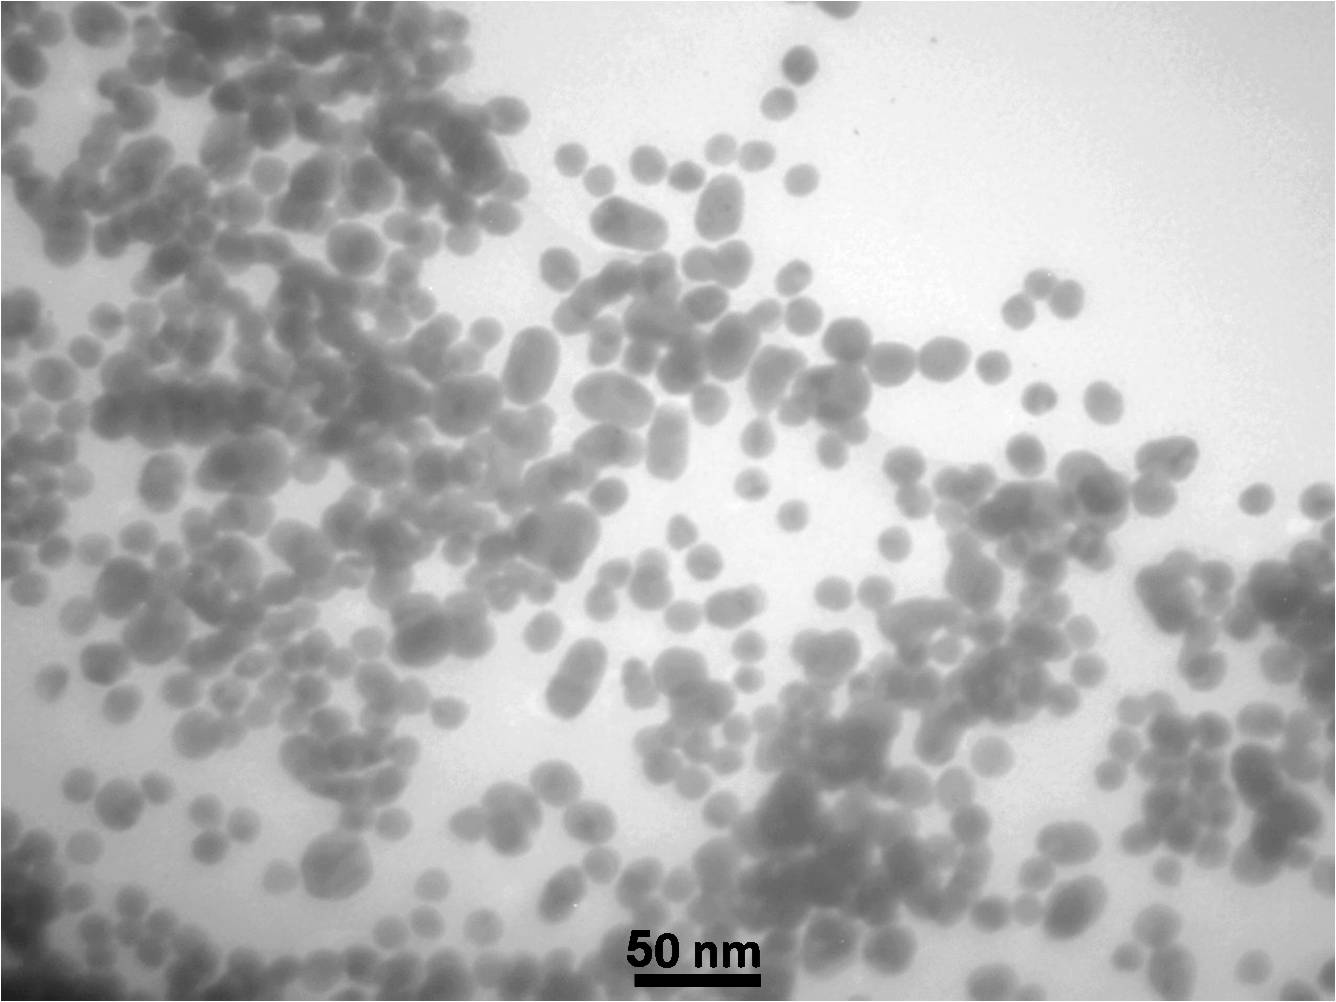
کلویید نانو ذرات طلا - تصویر 2

طلا عنصری در گروه فلزات میانی با ساختار مکعبی وجوه مرکز پر (FCC) است که در جواهرات، سکه، پزشکی، دندان پزشکی و تجهیزات الکترونیکی استفاده شده است. طلا یک فلز خنثی است که زنگ نزده و کدر نمی شود و دارای هدایت الکتریکی و حرارتی خوبی است. قرن ها طلا به عنوان فلزی ارزشمند و نانو ذرات کلوییدی طلا، به عنوان رنگ های درخشان توسط هنرمندان مورد استفاده قرار می گرفت. با تغییر در اندازه ذرات ، شیمی سطح یا حالت تجمع، خواص نوری و الکترونیکی نانو ذرات طلا قابل تغییر است.
خواص:
-
هدایت الکتریکی بالا
-
هدایت حرارتی بالا
-
رزونانس پلاسمای سطحی (Surface Plasmon Resonance)
-
زیست سازگار
کاربردها:
-
درمان های نوری-حرارتی سرطان یا بیماری های دیگر
-
آزادسازی کنترل شده داروها
-
ژن درمانی
-
حسگرهای زیستی
-
تشخیص بیماری و تصویربرداری x-ray
-
کاتالیزور نوری در صنایع شیمیایی
-
پوشش رسانا
این محصول با کیفیت تضمین شده (گارانتی کیفیت) ارائه می شود و در صورت عدم رضایت مشتری وجه پرداختی عودت داده می شود.
آنالیز و دیتاشیت محصول موجود می باشد
خلوص بالا و کیفیت ساختار مطلوب
ارائه نمونه رایگان برای خرید های عمده
| خصوصیات محصول | |
| شناسه محصول | AUP311 |
| فرمول شیمیایی | Au |
| شکل ظاهری | محلول |
| حلال | آب |
| رنگ | قرمز |
| شکل ذرات | کروی |
| اندازه ذرات | nm 5-20 |
| شرکت تولید کننده | مهندسی پایدار ابتکار آرمینا |
| علائم هشدار دهنده | |
| وزن | 0.1 کیلوگرم |
|---|---|
| بسته بندی | 100سی سی, 1 لیتری, 2.5 لیتری |